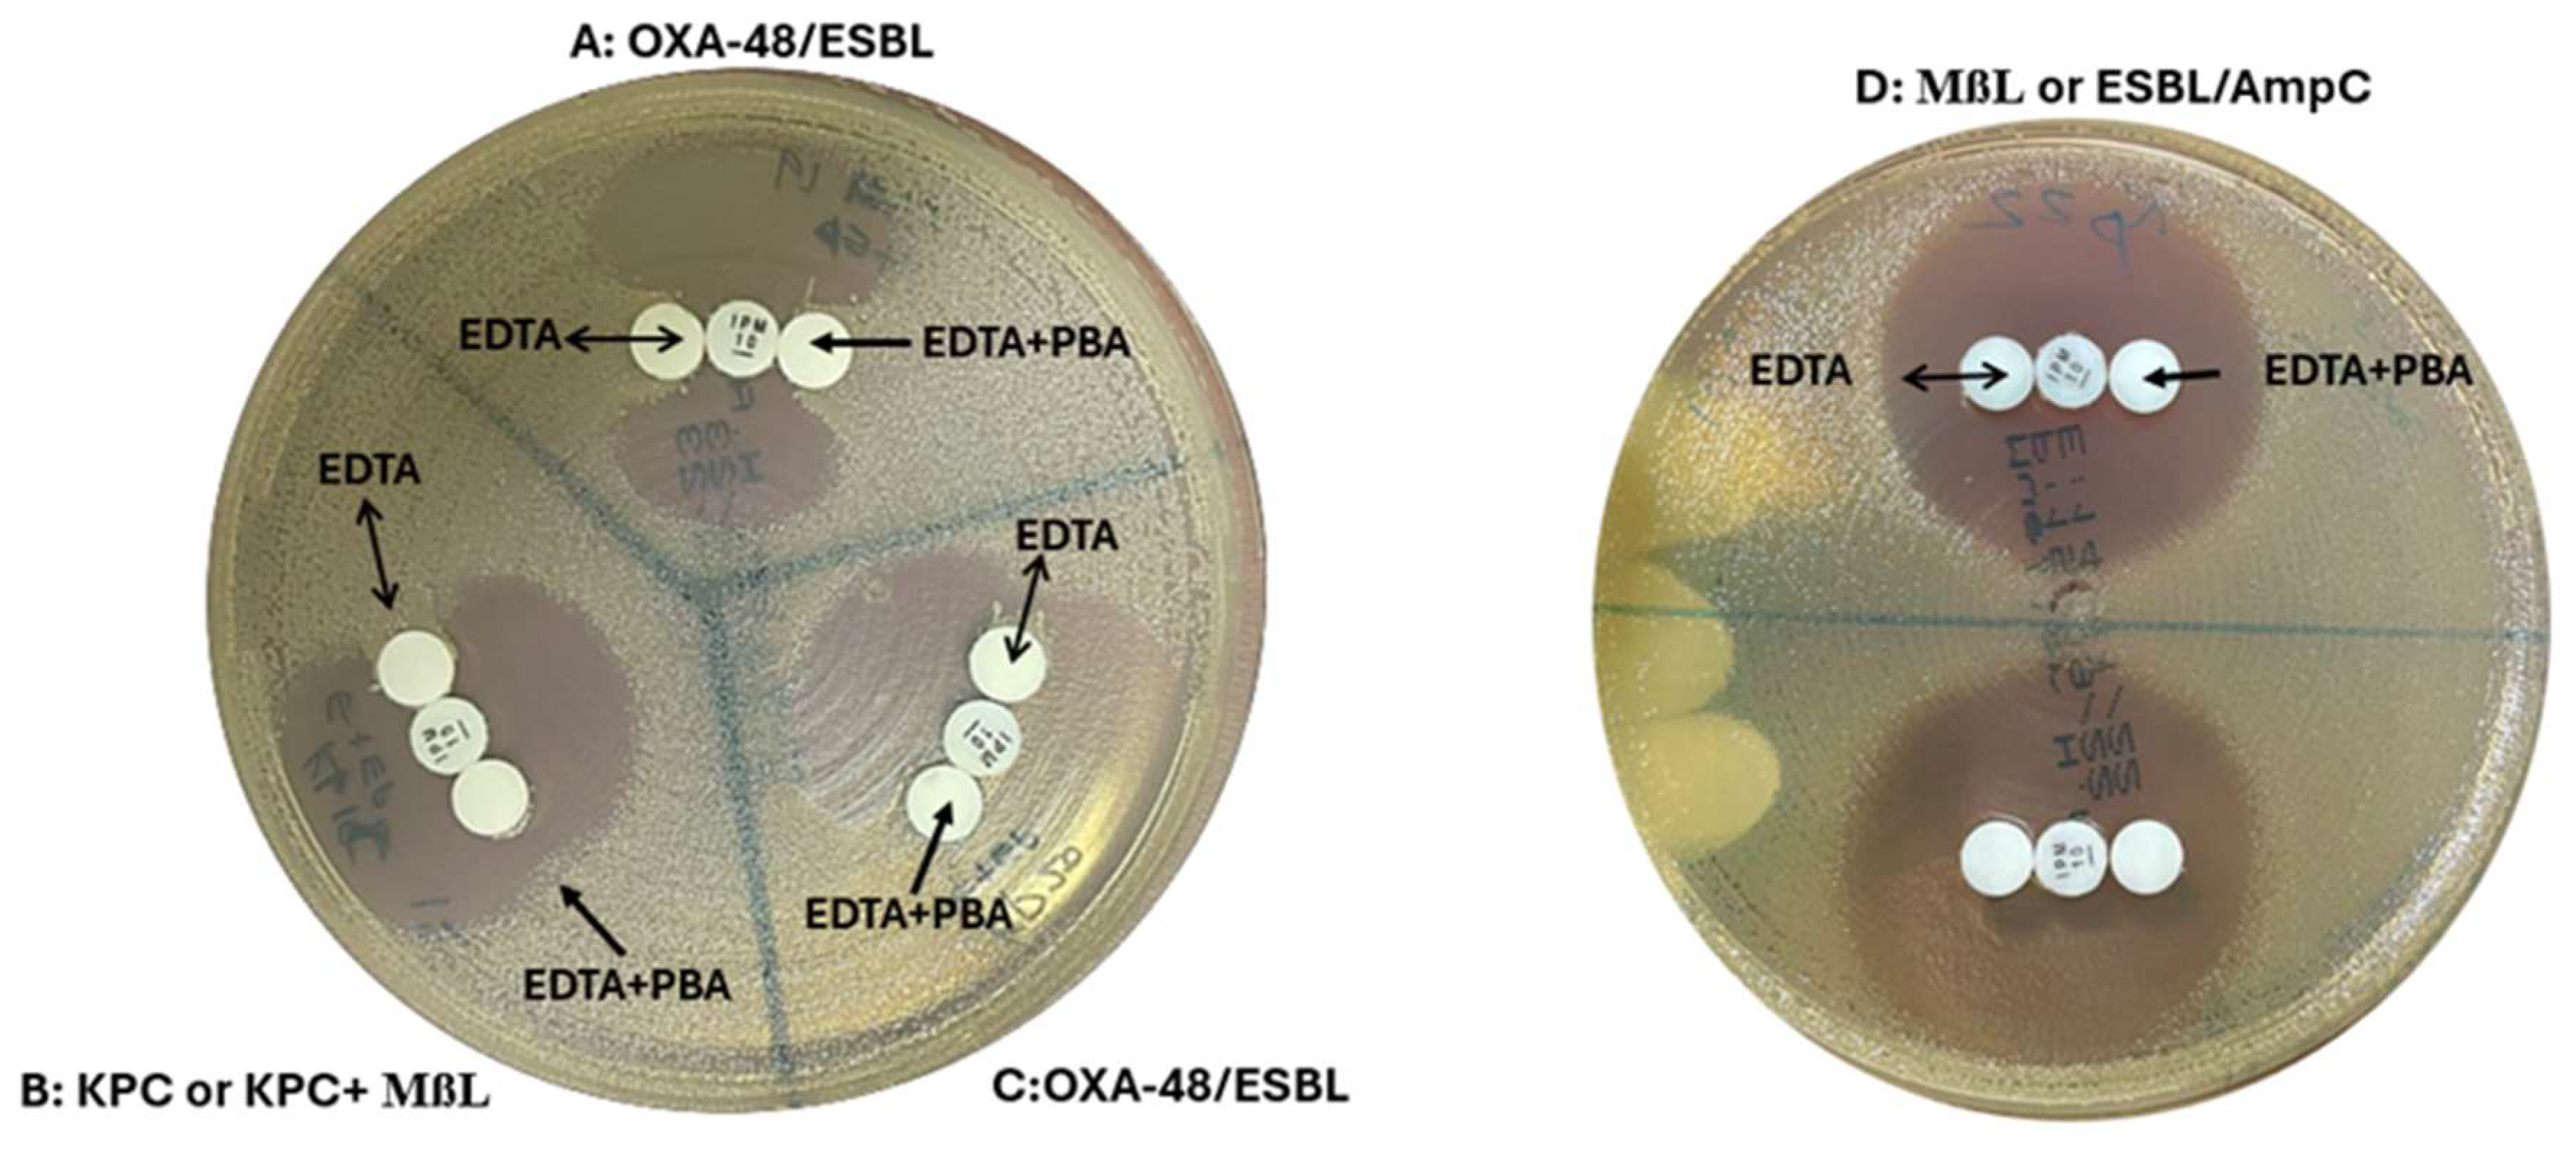
Preprints 146647 g003

1. Introduction
Carbapenemase-producing Enterobacterales (CRE) constitute a significant global public health threat in an era of spiraling antimicrobial resistance [
1]. In fact their incidence is on the rise in comparison to the total Enterobacterales infections with Klebsiella species predominating [
2,
3,
4,
5,
6]. Rapid detection of carbapenemases and initiation of appropriate antimicrobials improves patient outcomes, strengthens antimicrobial stewardship efforts and allows judicious use of the reserve antibiotics [
7]. Epidemiological studies indicate that as with other carbapenemases, OXA-48-producing strains are associated with poor patient outcomes. However, OXA-48 detection is rather challenging, due to low-level hydrolytic activity toward carbapenems and no intrinsic activity against expanded-spectrum cephalosporins [
6]. Initially reported in Turkey, OXA-48 prevalence has spread globally, with increasing reports in Europe, Asia, and North America [
8,
9]. In Oman, CRE was reported for the first time in 2011 among
Klebsiella pneumoniae harbouring NDM-1 and OXA-181 carbapenemases [
10]. Other reports described the molecular epidemiology of CRE in the country, where the predominant isolates were
Klebsiella pneumoniae, followed by
Escherichia coli,
Enterobacter cloacae and others that carried
blaNDM,
blaOXA48-like and to a lesser extent
blaVIM carbapenemases [
11]. In addition, Balkhair et al. reported in 2013 an overall prevalence rate of 10.8 (95% CI: 9.3–12.4) of multidrug resistant Gram-negative bacteria cases per 1,000 admissions [
12]. In 2012, 31 (24.0%) of 129 Enterobacterales strains recovered from a hospital in Muscat were CRE [
12]. In 2014, 1 (0.2%) of the 645 isolates recovered from Al-Buraimi Hospital was CRE [
13]. Moreover, the
blaOXA-48,
blaOXA-181,
blaOXA-232,
blaNDM-1 and
blaNDM-5 genes were detected in other studies [
14,
15,
16,
17]. While molecular methods are considered the gold standard for the detection of CRE, their accessibility is limited, particularly in resource constrained settings. [
18] This study aimed to evaluate several phenotypic tests for the detection of carbapenemases circulating in Oman with special focus on
blaOXA-48 in
K. pneumoniae, with the goal of identifying a rapid and reliable tool for detection of carbapenemases in general and OXA-48 like in particular.
2. Material and Methods
2.1. Sample Collection
A collaborative study was initiated between Sultan Qaboos University Hospital (SQUH) and Central of Public Health Laboratories (CPHL), Oman with the purpose of identifying a sensitive, specific and cost effective test for detection of OXA-48, KPC and NDM in K. pneumoniae which may be useful in low resource settings as well.One thousand and fifty five clinical isolates of K. pneumoniae obtained from SQUH and CPHL were screened for OXA-48 like, KPC and NDM over a six month period. All consecutive, non-duplicate i) meropenem and imipenem carbapenem resistant isolates. ii) isolates which demonstrated intermediate MICs to carbapenems, iii) resistance to piperacillin-tazobactam; iv) susceptible, intermediate, or resistant to third-generation cephalosporins.
2.2. Genotypic Confirmation of Carbapenemases
For genotypic confirmation of carbapenemases in CPHL, isolates were subjected to Gene Xpert ®Carba-R (Cepheid, Sunnyvale, CA) in SQUH or to PCR (Platinum multiplex PCR master mix, Thermofisher, Lithuania) In brief, at CPHL, the molecular analysis involved testing for the presence of carbapenemase genes: KPC, NDM, OXA-48 like, IMP and VIM. A pure isolate was used to extract the DNA, using QIAsymphony DSP DNA Mini Kit as per manufacturer’s instructions. Multiplex PCR targeted blaOXA-48, blaNDM, blaKPC, blaIMP and blaVIM. Gel electrophoresis was used for the molecular characterization of the CRE genes.
2.3. Whole Genome Sequencing (WGS)
Whole-genome sequencing (WGS) was performed at MicrobesNG using Illumina next-generation sequencing for representative OXA-48, KPC and NDM in
K. pneumoniae strains (
https://microbesng.co.uk, Birmingham, United Kingdom). The DNA samples were prepared and sequenced according to the manufacturer’s protocol. Post-sequencing, the samples were assembled using the De Novo assembly by the SPAdes program [
19] (Nurk et al., 2013). The assembled contigs were annotated with Prokka [
20] (Seemann, 2014) and uploaded to the website for further analysis. Detailed resistance gene profiling and bioinformatics analysis were conducted using the Center for Genomic Epidemiology (CGE) website (
https://www.genomicepidemiology.org/) [
21,
22]. This included identifying multi-locus sequence typing (MLST) with the MLST tool [
23].(Larsen et al., 2012), plasmids with the PlasmidFinder tool [
24].(Carattoli et al., 2014), and antibiotic resistance genes with the ResFinder tool [
25] (Bortolaia et al., 2020).
From the above mentioned pool, representative isolates from forty OXA-48-like, and twenty each of NDM and KPC carbapenemase producers and additionally 37 whole genome sequenced isolates (25 OXA-232, 6 KPC-2 plus NDM-1 and 6 NDM-5) were selected for evaluating the tests. OXA-232 harboured CTX-M-15, SHV-11, SHV-28, SHV-67, SHV-75, SHV106,SHV-182, while the KPC-2+NDM-1 carried CTMX-65, SHV-12, SHV-12, SHV-182 and SHV-182 and NDM-5 carried CTX-M-65, TEM-1B, TEM-1C, SHV-11, SHV-12, SHV-67, SHV-75.
2.4. Phenotypic Confirmation of Carbapenemases
First, all isolates were screened by one in-house test (temocillin disc test) and one commercial test (D71C). Subsequently, they were subjected to four confirmatory phenotypic tests to detect the presence of carbapenemases. The D72C MASTDISCS® Combi (MAST Group Ltd., UK) assay detected the presence of carbapenemases, as well as extended-spectrum beta-lactamases (ESBL) and AmpC enzymes, while the OXA-48 disc test, D73C MASTDISCS® Combi (MAST Group Ltd., UK), and the immunochromatographic KPC/IMP/NDM/VIM/OXA-48 Combo test kit (Medomics, China) were used to determine the specific carbapenemase type. Figure 1 shows the algorithm followed. Xpert ®Carba-R and WGS were used as the gold standard methods.
Figure 1.
Algorithm for screening and confirmation of carbapenemases.
Figure 1.
Algorithm for screening and confirmation of carbapenemases.
2.5. Screening Test:
Temocillin and D71C Disc Test
A 30 μg temocillin disc (MAST Group Ltd., UK) and faropenem disc from D71C (MAST Group Ltd., UK). were placed on a Mueller-Hinton plate inoculated with a fresh bacterial suspension equivalent to a 0.5 McFarland standard. Plates were incubated for 16 to 20 h under aerobic conditions at 35°C. An inhibition zone diameter of 11 mm for temocillin was considered positive for OXA-48 [
26,
27]. The CAT-ID (D71C) test was interpreted according to the manufacturer’s recommendation as follows: a clearly defined zone of inhibition was indicative of no carbapenemase activity; no zone of inhibition was indicative of MBL or KPC and single colonies in the zone of inhibition/double zone of inhibition was considered OXA-48 positive [
28]. (
Figure 2).
Figure 2.
Phenotypic tests used for detection of carbapenemase: (A) The screening tests (Temocillin and D71C): where temocillin inhibition zone was > 11 mm with no zone of inhibition around D71C (it was an indicative of MBL or KPC). (B) Screening plus confirmatory tests for NDM detection: Temocillin < 11 mm with no zone of inhibition around D71C and the confirmatory D73C was positive for NDM.
Figure 2.
Phenotypic tests used for detection of carbapenemase: (A) The screening tests (Temocillin and D71C): where temocillin inhibition zone was > 11 mm with no zone of inhibition around D71C (it was an indicative of MBL or KPC). (B) Screening plus confirmatory tests for NDM detection: Temocillin < 11 mm with no zone of inhibition around D71C and the confirmatory D73C was positive for NDM.
2.6. Confirmatory Tests:
OXA-48 Disk Test
OXA-48 disk test is based on utilization of EDTA to permeabilize bacterial cells, releasing β-lactamases into the environment. EDTA also inhibits MBL carbapenemases, while PBA inhibits KPCs. A 0.1 M EDTA stock solution was prepared by dissolving anhydrous EDTA in distilled water [
29]. From this, 10 µl (292 µg of EDTA) was dispensed onto two blank paper disks. A PBA stock solution was made by dissolving PBA in dimethyl sulfoxide and water at 60 mg/ml [
30]. From this, 10 µl (600 µg of PBA) was added to the EDTA disks. The disks were dried and used within 60 minutes. A Mueller-Hinton agar plate was inoculated with carbapenem-susceptible
E. coli ATCC 25922 at 0.5 McFarland standard turbidity. A 10-µg imipenem disk was placed on the agar surface. Four to six colonies of the test microorganism were applied to the EDTA and EDTA plus PBA disks, which were then placed inoculum-side down on the lawn adjacent to the imipenem disk. The plate was incubated overnight at 35°C in ambient air. After 18 hours, the plates were examined for an indentation or flattening of the inhibition zone. Indentation towards both EDTA and EDTA/PBA disks indicated OXA-48 carbapenemase production. Indentation towards the EDTA disk but not the EDTA/PBA disks suggested KPC or KPC plus MBL production. No growth towards both disks indicated MßL carbapenemase production or carbapenem non-susceptibility due to ESBL/AmpC production plus porin loss [
31] (
Figure 3).
Figure 3.
OXA-48 Disk test: (A,C) Indentation towards both EDTA and EDTA/PBA disks indicated OXA-48 carbapenemase production. (B) Indentation towards the EDTA disk but not the EDTA/PBA disks suggested KPC or KPC plus MBL production. (D) No growth towards both disks indicated MßL carbapenemase production or carbapenem non-susceptibility due to ESBL/AmpC production plus porin loss.
Figure 3.
OXA-48 Disk test: (A,C) Indentation towards both EDTA and EDTA/PBA disks indicated OXA-48 carbapenemase production. (B) Indentation towards the EDTA disk but not the EDTA/PBA disks suggested KPC or KPC plus MBL production. (D) No growth towards both disks indicated MßL carbapenemase production or carbapenem non-susceptibility due to ESBL/AmpC production plus porin loss.
MASTDISCS® Combi (D72C): AmpC, ESBL & Carbapenemase Detection Set
The AmpC, ESBL & Carbapenemase Detection set D72C (Mast Group Ltd., UK), is designed to detect ESBL and or AmpC (both chromosomal and plasmid-mediated), and the co-production of ESBL and AmpC enzymes, as well as carbapenem resistance status in Enterobacteriaceae. This set includes six cartridges: cartridge A (cefpodoxime 10 μg), cartridge B (cefpodoxime 10 μg + ESBL inhibitor), cartridge C (cefpodoxime 10 μg + AmpC inhibitor), cartridge D (cefpodoxime 10 μg + ESBL inhibitor + AmpC inhibitor), cartridge E (cefpodoxime 10 μg + ESBL inhibitor + AmpC inducer), cartridge F (penem antibiotic). The procedure was executed, and the results were analyzed in accordance with the manufacturer’s instructions [
32,
33].
MASTDISCS® Combi Carba Plus (D73C)
The Carba plus (D73C) (Mast Group Ltd., UK), is designed to detect carbapenemase and OXA-48 enzyme production in Enterobacterales. This set includes five cartridges: cartridge A (penem), cartridge B (penem+ MßL inhibitor), cartridge C (penem+ KPC inhibitor), cartridge D (penem+ AmpC inhibitor), cartridge E (Temocillin + MßL inhibitor). The procedure was executed, and the results were analyzed in accordance with the manufacturer’s instructions.
Immunochromatographic Assay (ICT)
The KPC/IMP/NDM/VIM/OXA-48 Combo test kit (Medomics, Nanjing, China) is a lateral flow colloidal gold immunochromatographic assay (LFIA) designed to specifically detect the five most common carbapenemases (KPC, IMP, NDM, VIM, and OXA-48) using a double antibody sandwich method [
34,
35,
36]. The procedure was carried out and the results were interpreted according to the manufacturer’s guidelines (
Figure 4).
Figure 4.
Immunochromatographic assay (ICT)where: (A) O line indicated positive result for OXA-48 carbapenemase; (B) N line indicated positive result for NDM carbapenemase; (C) K line and N line indicated positive results for both KPC+NDM.
Figure 4.
Immunochromatographic assay (ICT)where: (A) O line indicated positive result for OXA-48 carbapenemase; (B) N line indicated positive result for NDM carbapenemase; (C) K line and N line indicated positive results for both KPC+NDM.
2.7. Statistical Analysis
Data analysis was carried out by IBM SPSS Statistics for Windows Version 25.0. (IBM Corp, 2017). Chi-square test was used to compare categorical data between two groups. Cross-tabulation was used taking WGS, Xpert ®Carba-R and ICT as a gold standard to determine the sensitivity and specificity. Positive predictive value (PPV) and negative predictive value (NPV) were calculated.
3. Results
The screening and confirmatory tests were evaluated against Xpert ®Carba-R/PCR and WGS confirmed carbapenemase (OXA-48 like, KPC and NDM) producing strains.
3.1. Screening Tests
D71C identified all except one isolate as a carbapenemase-producer. Temocillin disc test identified OXA-48 in all 40 (100%) OXA-48 positive strains. KPC and NDM were identified in 18/20 (90%) each. (
Table 1) All OXA-232 were also identified as OXA-48 while 4/6 isolates co-harbouring KPC-2 and NDM-1 were identified as KPC. Only 1 out of 6 NDM-5 isolates were identified as NDM (
Table 2). OXA-48 like producers demonstrated complete temocillin resistance. (inhibition zone: 6 mm), far below the cutoff of 11 mm. It was observed that the KPCs and NDMs too demonstrated inhibition zones below the cut off values but near 11mm [
37].
Table 1.
Assessment of phenotypic tests for detection of OXA-48, KPC and NDM in Klebsiella pneumoniae using Xpert ®Carba-R/PCR as gold standard.
Table 1.
Assessment of phenotypic tests for detection of OXA-48, KPC and NDM in Klebsiella pneumoniae using Xpert ®Carba-R/PCR as gold standard.
Table 2.
Assessment of phenotypic tests for detection of OXA-232, KPC-2+NDM-1 and NDM-5 in Klebsiella pneumoniae using WGS as gold standard.
Table 2.
Assessment of phenotypic tests for detection of OXA-232, KPC-2+NDM-1 and NDM-5 in Klebsiella pneumoniae using WGS as gold standard.
3.2. Confirmatory Tests
OXA-48 Disk Test
This test correctly identified 38/40 (95%) isolates as OXA-48 like, exhibiting high sensitivity (100% and 92.5%) and specificity (91.67% and 100%) with WGS and Xpert ®Carba-R/PCR as gold standards, respectively as seen in Table 3. The negative predictive value (NPV) was 100% for WGS and 93.02% for Xpert ®Carba-R/PCR. Two false-positive isolates producing OXA-48 tested negative OXA-232 were identified as OXA-48 in 22/25 (88%) cases. It correctly identified all NDMs and KPCs. Five of the six isolates co-harbouring NDM-1 and KPC-2 were identified as KPC and all NDM-5s as NDM. Overall, the OXA-48 disk test showed high sensitivity across all groups: OXA-48: 38/40 (95%) and KPC and NDM: 20/20 (100%).
Table 3.
Sensitivity and specificity of phenotypic tests for detection of OXA-48 like, KPC and NDM using WGS, Xpert ®Carba-R and ICT as the gold standards.
Table 3.
Sensitivity and specificity of phenotypic tests for detection of OXA-48 like, KPC and NDM using WGS, Xpert ®Carba-R and ICT as the gold standards.
D72C Test
The D72C test detected the presence of a carbapenemase in 79/80 (OXA-48 like, KPC and NDM) as well as 25 OXA-232, 6 NDM-5 and 6 isolates co-carrying NDM-1 and KPC-2, missing only one OXA-48 like K. pneumoniae. It had high sensitivity (100% with WGS as gold standard and 97.50% with Xpert ®Carba-R/PCR), Specificity and PPV was 100% against both and NPV (100% and 97.5%).
D73C Test
D73C showed slightly higher sensitivity (95%) compared to the OXA-48 disk test (92.5% with Xpert ®Carba-R/PCR but lower (96%) with WGS. In comparison to the OXA-48 disk test D73C had lower specificity (91.67%) across both gold standards. PPV was 96.15%, 95% and NPV was 91.67% for both gold standards. Similar to the OXA-48 disk test, this test missed one OXA-232 and one isolate which co-harboured NDM-1 and KPC-2.
ICT Test
ICT detected all OXA-48 like isolates but missed one KPC and NDM each. It demonstrated 100% sensitivity and NPV against both gold standards and 92%, 95% specificity with 96.15%, 95.24% PPV. Among the sequenced strains, it missed one isolate which co-harboured NDM-1 and KPC-2 but identified all OXA-232 and NDM-5.
4. Discussion
Identifying the precise carbapenemase enzyme is essential for optimising patient care and promoting appropriate antimicrobial stewardship efforts. In many parts of the world and particularly the Middle East, OXA-48 like carbapenemase predominates followed by NDM and KPC [
9]. Amongst these, phenotypic detection of OXA-48 like carbapenemase is particularly challenging. While Xpert
®Carba-R/PCR and WGS are preferred tools for detecting them, they are expensive and not readily available in most diagnostic laboratories, particularly in the low- and medium-income countries (LMICs). In this study, we tested an array of commercial and in-house screening and confirmatory tests and assessed their utility in detecting different carbapenemases with a particular focus on OXA-48 like genes.
Temocillin disc test proved to be a good, simple and cheap screening test for carbapenemases, with a good discriminatory index in detecting OXA-48. It exhibited 100% sensitivity for OXA-48 detection, and 90% for KPCs and NDMs [
28]. On the other hand D71C achieved 100% sensitivity for the latter two and 97.5% for OXA-48 like carbapenemases [
37].
This study reveals that the OXA-48 disk test is a reliable and cost effective method for detecting carbapenemases in general and OXA-48 in particular. With high sensitivity (100%, 92.5%) and specificity (91.67%, 100%) with WGS and Xpert
®Carba-R/PCR as gold standard, OXA-48 disk test is a valuable tool for detecting OXA-48, KPC and NDM carbapenemases, in clinical laboratories especially in resource constrained settings. Tsakris et al. reported a 96.3% sensitivity and 97.7% specificity [
31]. However, Koroska et al. reported a lower sensitivity of 53.6% which improved to 98.8% when a high inoculum was used [
37]. In this study too, a higher inoculum (4-6 colonies) yielded better results. The OXA-48 disk test is a cheap test, but needs to be validated in individual laboratories which is time consuming and correct interpretation requires experience. Poor detection rate of co-carriage of dual carbapenemases is a distinct limitation of this test [
37].
While the D72C test is an excellent tool for detecting ESBL, AmpC and carbapenemases with good reproducibility and discrimination, it does not identify the type of carbapenemase which is a disadvantage. For detecting carbapenemases in general, it had high sensitivity (100%, 97.50%) with WGS and GeneXpert gold standards, with 100% specificity. Another study reported a lower sensitivity (90%) for carbapenemase detection [
32]. In a comparative evaluation of various phenotypic tests, the D72C test achieved an accuracy of 95.4% for detecting AmpC and carbapenemase production.[
33].
The D73C test supersedes D71C entirely and if used in conjunction with D72C which detects ESBL and AmpC as well, it could promote antimicrobial stewardship considerably. Although this combination does increase the cost, the benefit of identifying ESBL and AmpC and instituting appropriate antimicrobials may outweigh the incurred cost. However, ESBL and AmpC can be detected by cheap and easy in-house tests as well. Al Mamari et al. demonstrated that D73C was slightly inferior to the OXA-48-disc test with 96% sensitivity and 100% specificity with WGS as gold standard [
33]. However, it has an advantage over D71C and D72C that it identifies the carbapenemase types. All (100%) OXA-48 and OXA-232 were identified as OXA-48 like. It demonstrated high sensitivity (97.5% for OXA-48, 100% for NDM) and 91.67% specificity, making it highly accurate. The negative predictive values were comparable, although lower in D73C (91.67%), indicating that while both tests are effective, the OXA-48-disc test may offer more reliable results overall, once appropriately standardised.
ICT with 100% sensitivity and 100% specificity
, surpassed both the in-house OXA-48-disc test and the D73C in performance, making it the gold standard among phenotypic tests. Compared to Xpert
®Carba-R, ICT is superior in specificity but slightly weaker in sensitivity. With other commercial phenotypic tests being time-consuming and expensive ICT provides rapid results within 20 minutes at a moderate cost. Molecular tests with comparable sensitivity and specificity are expensive and not widely available in most parts of the world [
7]. Of course, for maximal detection accuracy, WGS remains the ideal gold standard although Xpert
®Carba-R and ICT have excellent sensitivity, specificity, reproducibility and discrimination [
37].
5. Conclusions
Temocillin offers a degree of discrimination of carbapenemase type, especially for OXA-48 and we recommend that it may be incorporated in the laboratory as a screening tool. Excellent sensitivity and specificity, rapid results, ease of performance, and relatively low cost makes ICT an excellent tool for detection of carbapenemases in diagnostic laboratories. This test has the potential to be a game changer in optimising patient care and promoting antimicrobial stewardship at scale. OXA-48 disc test is an excellent tool too and will serve well in resource constrained centres. We believe that in-house screening and confirmatory tests are both equally sensitive and specific as the commercial tests. Hence depending on the resources, laboratories may exercise their discretion and adopt appropriate tests to identify the carbapenemase types and promote antimicrobial stewardship and optimum patient management.
Author Contributions
Conceptualization, M.R. and A.A.R.; data curation, A.A.R. and Z.A.J.; formal analysis, M.R. and A.A.R.; investigation, A.A.R. and Z.A.J.; methodology, M.R.; writing—original draft preparation, A.A.R.; writing—review and editing, A.A.R, Z.A.I, A.A.J, A.A.R, A.A.M, S.A.A, H.S and M.R.; supervision, M.R. All authors have read and agreed to the published version of the manuscript.
Funding
This study was funded by the Ministry of Higher Education Research & Innovation (MoHERI) under the Block-Funding program (RC/GRG-MED/MICR/21/01).
Conflicts of Interest
The authors have no conflicts of interest to declare.
References
- Bakthavatchalam, Y. D., Anandan, S., & Veeraraghavan, B. (2016). Laboratory Detection and Clinical Implication of Oxacillinase-48 like Carbapenemase: The Hidden Threat. 41–50. [CrossRef]
- Nordmann P, Cuzon G, Naas T. The real threat of Klebsiella pneumoniae carbapenemase-producing bacteria. Lancet Infect Dis. 2009;9(4):228–36. [CrossRef]
- Pitout JDD, Nordmann P, Poirel L. Carbapenemase-producing Klebsiella pneumoniae, a key pathogen set for global nosocomial dominance. Antimicrob Agents Chemother. 2015;59(10). [CrossRef]
- Barguigua A, Zerouali K, Katfy K, El Otmani F, Timinouni M, Elmdaghri N. Occurrence of OXA-48 and DM-1 carbapenemase-producing Klebsiella pneumoniae in a Moroccan university hospital in Casablanca, Morocco. Infection, Genetics and Evolution. 2015;31:142-8. [CrossRef]
- Solgi H, Badmasti F, Giske CG, Aghamohammad S, Shahcheraghi F. Molecular epidemiology of NDM-1-and OXA-48-producing Klebsiella pneumoniae in an Iranian hospital: clonal dissemination of ST11 and ST893. Journal of Antimicrobial Chemotherapy. 2018;73(6):1517-24. [CrossRef]
- Stewart A, Harris P, Henderson A, Paterson D. 2018. Treatment of infections by OXA-48-producing Enterobacteriaceae. Antimicrob Agents Chemother 62:e01195-18. [CrossRef]
- Greissl, C., Saleh, A., & Hamprecht, A. (2019). Rapid detection of OXA-48-like, KPC, NDM, and VIM carbapenemases in Enterobacterales by a new multiplex immunochromatographic test. European Journal of Clinical Microbiology & Infectious Diseases, 38(3), 331-335. [CrossRef]
- Day, K. M. Day, K. M., Sidjabat, H. E., & Kamolvit, W. (2014). Evaluation of a new chromogenic medium, chromID OXA-48, for recovery of carbapenemase-producing Enterobacteriaceae from patients at a university hospital in Turkey Laboratory Protocol for Detection of Carbapenem-Resistant or Carbapenemase-Producing, Klebsiella spp. and E. coli from Rectal Swabs Purpose. October. [CrossRef]
- Boyd SE,,Holmes A,Peck R,Livermore DM, Hope W. 2022. OXA-48-Like β-Lactamases: Global Epidemiology, Treatment Options, and Development Pipeline. Antimicrob Agents Chemother 66:e00216-22. [CrossRef]
- Poirel, L. , Al Maskari, Z., Al Rashdi, F., Bernabeu, S., & Nordmann, P. (2011). NDM-1-producing Klebsiella pneumoniae isolated in the Sultanate of Oman. Journal of Antimicrobial Chemotherapy, 66(2), 304-306. [CrossRef]
- Sonnevend, A. , Ghazawi, A. A., Hashmey, R., Jamal, W., Rotimi, V. O., Shibl, A. M.,... & Pál, T. (2015). Characterization of carbapenem-resistant Enterobacteriaceae with high rate of autochthonous transmission in the Arabian Peninsula. PloS one, 10(6), e0131372. [CrossRef]
- Balkhair, A. , Al-Farsi, Y. M., Al-Muharrmi, Z., Al-Rashdi, R., Al-Jabri, M., Neilson, F.,... & Al-Adawi, S. (2014). Epidemiology of multi-drug resistant organisms in a teaching hospital in Oman: a one-year hospital-based study. The Scientific World Journal, 2014. [CrossRef]
- Khalid, M. , Al Naimi, M. K., Murtaza Saleem, H. G., Ullah, M. M., Baloshi, A., & Dawood, A. Y. M. (2017). Antibiotics Resistance Profile of Uropathogens Isolated from Al Buraimi Hospital, Sultanate of Oman. Global journal of health science, 10(1), 98. [CrossRef]
- Dortet, L. , Poirel, L., Al Yaqoubi, F., & Nordmann, P. (2012). NDM-1, OXA-48 and OXA-181 carbapenemase-producing Enterobacteriaceae in Sultanate of Oman. Clinical Microbiology and Infection, 18(5), E144-E148. [CrossRef]
- Al-Farsi HM, Camporeale A, Ininbergs K, Al-Azri S, Al-Muharrmi Z, Al-Jardani A, et al. (2020) Clinical and molecular characteristics of carbapenem non-susceptible Escherichia coli: A nationwide survey from Oman. PLoS ONE 15(10): e0239924. [CrossRef]
- AL-Quraini, M. , Rizvi, M., AL-Jabri, Z., Sami, H., AL-Muzahmi, M., AL-Muharrmi, Z., Taneja, N., AL-Busaidi, I., & Soman, R. (2022). Assessment of In-Vitro Synergy of Fosfomycin with Meropenem, Amikacin and Tigecycline in Whole Genome Sequenced Extended and Pan Drug Resistant Klebsiella Pneumoniae: Exploring A Colistin Sparing Protocol. Antibiotics, 11(2), 153. [CrossRef]
- Al-Muzahmi, M. , Rizvi, M., Al-Quraini, M., Al-Muharrmi, Z., & Al-Jabri, Z. (2023). Comparative Genomic Analysis Reveals the Emergence of ST-231 and ST-395 Klebsiella pneumoniae Strains Associated with the High Transmissibility of blaKPC Plasmids. Microorganisms, 11(10), 2411. [CrossRef]
- Van Der Zee, A. , Roorda, L., Bosman, G., Fluit, A. C., Hermans, M., Smits, P. H. M., Van Der Zanden, A. G. M., Witt, R., Van Es, L., Van Coppenraet, B., & Stuart, J. C. (2014). Multi-centre evaluation of real-time multiplex PCR for detection of carbapenemase genes OXA-48, VIM, IMP, NDM and KPC. BMC Infectious Diseases. [CrossRef]
- Nurk, S., Bankevich, A., Antipov, D., Gurevich, A. A., Korobeynikov, A., Lapidus, A., ... & Pevzner, P. A. (2013). Assembling genomes and mini-metagenomes from highly chimeric reads. Nature Biotechnology, 31(12), 1084-1091. [CrossRef]
- Seemann, T. (2014). Prokka: rapid prokaryotic genome annotation. Bioinformatics, 30(14), 2068-2069. [CrossRef]
- Al-Zahrani IA, Aljabri A, Alhazmi WA, Yasir M, Abujamel T, Alghamdi AK, Azhar EI. Genomic analysis of extensively drug resistant (XDR) Klebsiella pneumoniae high-risk clone ST14 co-harboring blaNDM and blaOXA-48 recovered from Saudi Arabia. Journal of Infection and Public Health. 2024;17(4):669 – 75. [CrossRef]
- Uelze, L., Grützke, J., Borowiak, M., Hammerl, J. A., Juraschek, K., Deneke, C., Tausch, S. H., & Malorny, B. (2020). Typing methods based on whole genome sequencing data. One Health Outlook, 2, 3. [CrossRef]
- Larsen, M. V., Cosentino, S., Rasmussen, S., Friis, C., Hasman, H., Marvig, R. L., ... & Aarestrup, F. M. (2012). Multilocus sequence typing of total-genome-sequenced bacteria. Journal of Clinical Microbiology, 50(4), 1355-1361. [CrossRef]
- Carattoli, A., Zankari, E., García-Fernández, A., Voldby Larsen, M., Lund, O., Villa, L., ... & Hasman, H. (2014). In silico detection and typing of plasmids using PlasmidFinder and plasmid multilocus sequence typing. Antimicrobial Agents and Chemotherapy, 58(7), 3895-3903. [CrossRef]
- Bortolaia, V. Bortolaia, V., Kaas, R. S., Ruppe, E., Roberts, M. C., Schwarz, S., Cattoir, V., ... & Aarestrup, F. M. (2020). ResFinder 4.0 for predictions of phenotypes from genotypes. Journal of Antimicrobial Chemotherapy, 75(12), 3491-3500. [CrossRef]
- Giske, C. G. Giske, C. G., Martinez-Martinez, L., Canton, R., Stefani, S., Skov, R., Glupczynski, Y., Nordmann, P., Wootton, M., Miriagou, V., Skov Simonsen, G., Zemlickova, H., Cohen-Stuart, J., & Gniadkowski, M. (2013). EUCAST guidelines for detection of resistance mechanisms and specific resistances of clinical and/or epidemiological importance, version 1.0. Retrieved from http://www.eucast.org/fileadmin/src/media/PDFs/EUCAST_files/Resistance_mechanisms/EUCAST_detection_of_resistance_mechanisms_v1.0_20131211.pdf.
- Van Dijk, K., Voets, G. M., Scharringa, J., Voskuil, S., Fluit, A. C., Rottier, W. C., Leverstein-Van Hall, M. A., & Cohen Stuart, J. W. (2014). A disc diffusion assay for detection of class A, B and OXA-48 carbapenemases in Enterobacteriaceae using phenyl boronic acid, dipicolinic acid and temocillin. Clinical microbiology and infection : the official publication of the European Society of Clinical Microbiology and Infectious Diseases, 20(4), 345–349. [CrossRef]
- Shaker, O. A., Gomaa, H. E. E. D., ElMasry, S. A., Abdel Halim, R. M., & Abdelrahman, A. H. (2018). Evaluation of Combined Use of Temocillin Disk and Mastdisks Inhibitor Combination Set Against Polymerase Chain Reaction for Detection of Carbapenem-Resistant Enterobacteriaceae. Open Access Macedonian Journal of Medical Sciences, 6(2). [CrossRef]
- Franklin, C., Liolios, L., & Peleg, A. Y. (2006). Phenotypic detection of carbapenem-susceptible metallo-β-lactamase-producing gram-negative bacilli in the clinical laboratory. Journal of Clinical Microbiology, 44(9), 3139–3144. [CrossRef]
- Tsakris, A., Kristo, I., Poulou, A., Themeli-Digalaki, K., Ikonomidis, A., Petropoulou, D., Pournaras, S., & Sofianou, D. (2009). Evaluation of boronic acid disk tests for differentiating KPC-possessing Klebsiella pneumoniae isolates in the clinical laboratory. Journal of Clinical Microbiology, 47(2), 362–367. [CrossRef]
- Tsakris, A., Poulou, A., Bogaerts, P., Dimitroulia, E., Pournaras, S., & Glupczynski, Y. (2015). Evaluation of a New Phenotypic OXA-48 Disk Test for Differentiation of OXA-48 Carbapenemase-Producing Enterobacteriaceae Clinical Isolates. Journal of Clinical Microbiology, 53(4), 1245-1251. [CrossRef]
- Noubam-Tchatat, C. C., Maurin, E., Proust, S., Beyrouthy, R., Bonnet, R., & Robin, F. (2024). MAST® D72C test: A novel option for ESBL, AmpC and carbapenemase detection. European Journal of Clinical Microbiology & Infectious Diseases, 43(6), 1181-1192. [CrossRef]
- Al Mamari, A. M. K., Al Jabri, Z., Sami, H., Rizvi, S. G. A., Chan, M. F., Al Siyabi, T., Al Muharrmi, Z., & Rizvi, M. (2023). Evaluation of six commercial and in-house phenotypic tests for detection of AmpC β-lactamases: Is routine detection possible? JAC Antimicrobial Resistance, 5(5), dlad101. [CrossRef]
- Han, R., Guo, Y., Peng, M., Shi, Q., Wu, S., Yang, Y., Zheng, Y., Yin, D., & Hu, F. (2021). Evaluation of the Immunochromatographic NG-Test Carba 5, RESIST-5 O.O.K.N.V., and IMP K-SeT for Rapid Detection of KPC-, NDM-, IMP-, VIM-type, and OXA-48-like Carbapenemase Among Enterobacterales. Frontiers in Microbiology, 11, 609856. [CrossRef]
- Saleh, A., Göttig, S., & Hamprecht, A. G. (2018). Multiplex Immunochromatographic Detection of OXA-48, KPC, and NDM Carbapenemases: Impact of Inoculum, Antibiotics, and Agar. Journal of Clinical Microbiology, 56(10), e00050-18. [CrossRef]
- Bogaerts, P., Berger, A. S., Evrard, S., & Huang, T. D. (2020). Comparison of two multiplex immunochromatographic assays for the rapid detection of major carbapenemases in Enterobacterales. Journal of Antimicrobial Chemotherapy, 75(6), 1491–1494. [CrossRef]
- Koroska, F., Göttig, S., Kaase, M., Steinmann, J., Gatermann, S., Sommer, J., Wille, T., Plum, G., & Hamprecht, A. (2017). Comparison of Phenotypic Tests and an Immunochromatographic Assay and Development of a New Algorithm for Detection of OXA-48-like Carbapenemases. Journal of Clinical Microbiology, 55(3). [CrossRef]
|
Disclaimer/Publisher’s Note: The statements, opinions and data contained in all publications are solely those of the individual author(s) and contributor(s) and not of MDPI and/or the editor(s). MDPI and/or the editor(s) disclaim responsibility for any injury to people or property resulting from any ideas, methods, instructions or products referred to in the content. |
© 2025 by the authors. Licensee MDPI, Basel, Switzerland. This article is an open access article distributed under the terms and conditions of the Creative Commons Attribution (CC BY) license (http://creativecommons.org/licenses/by/4.0/).